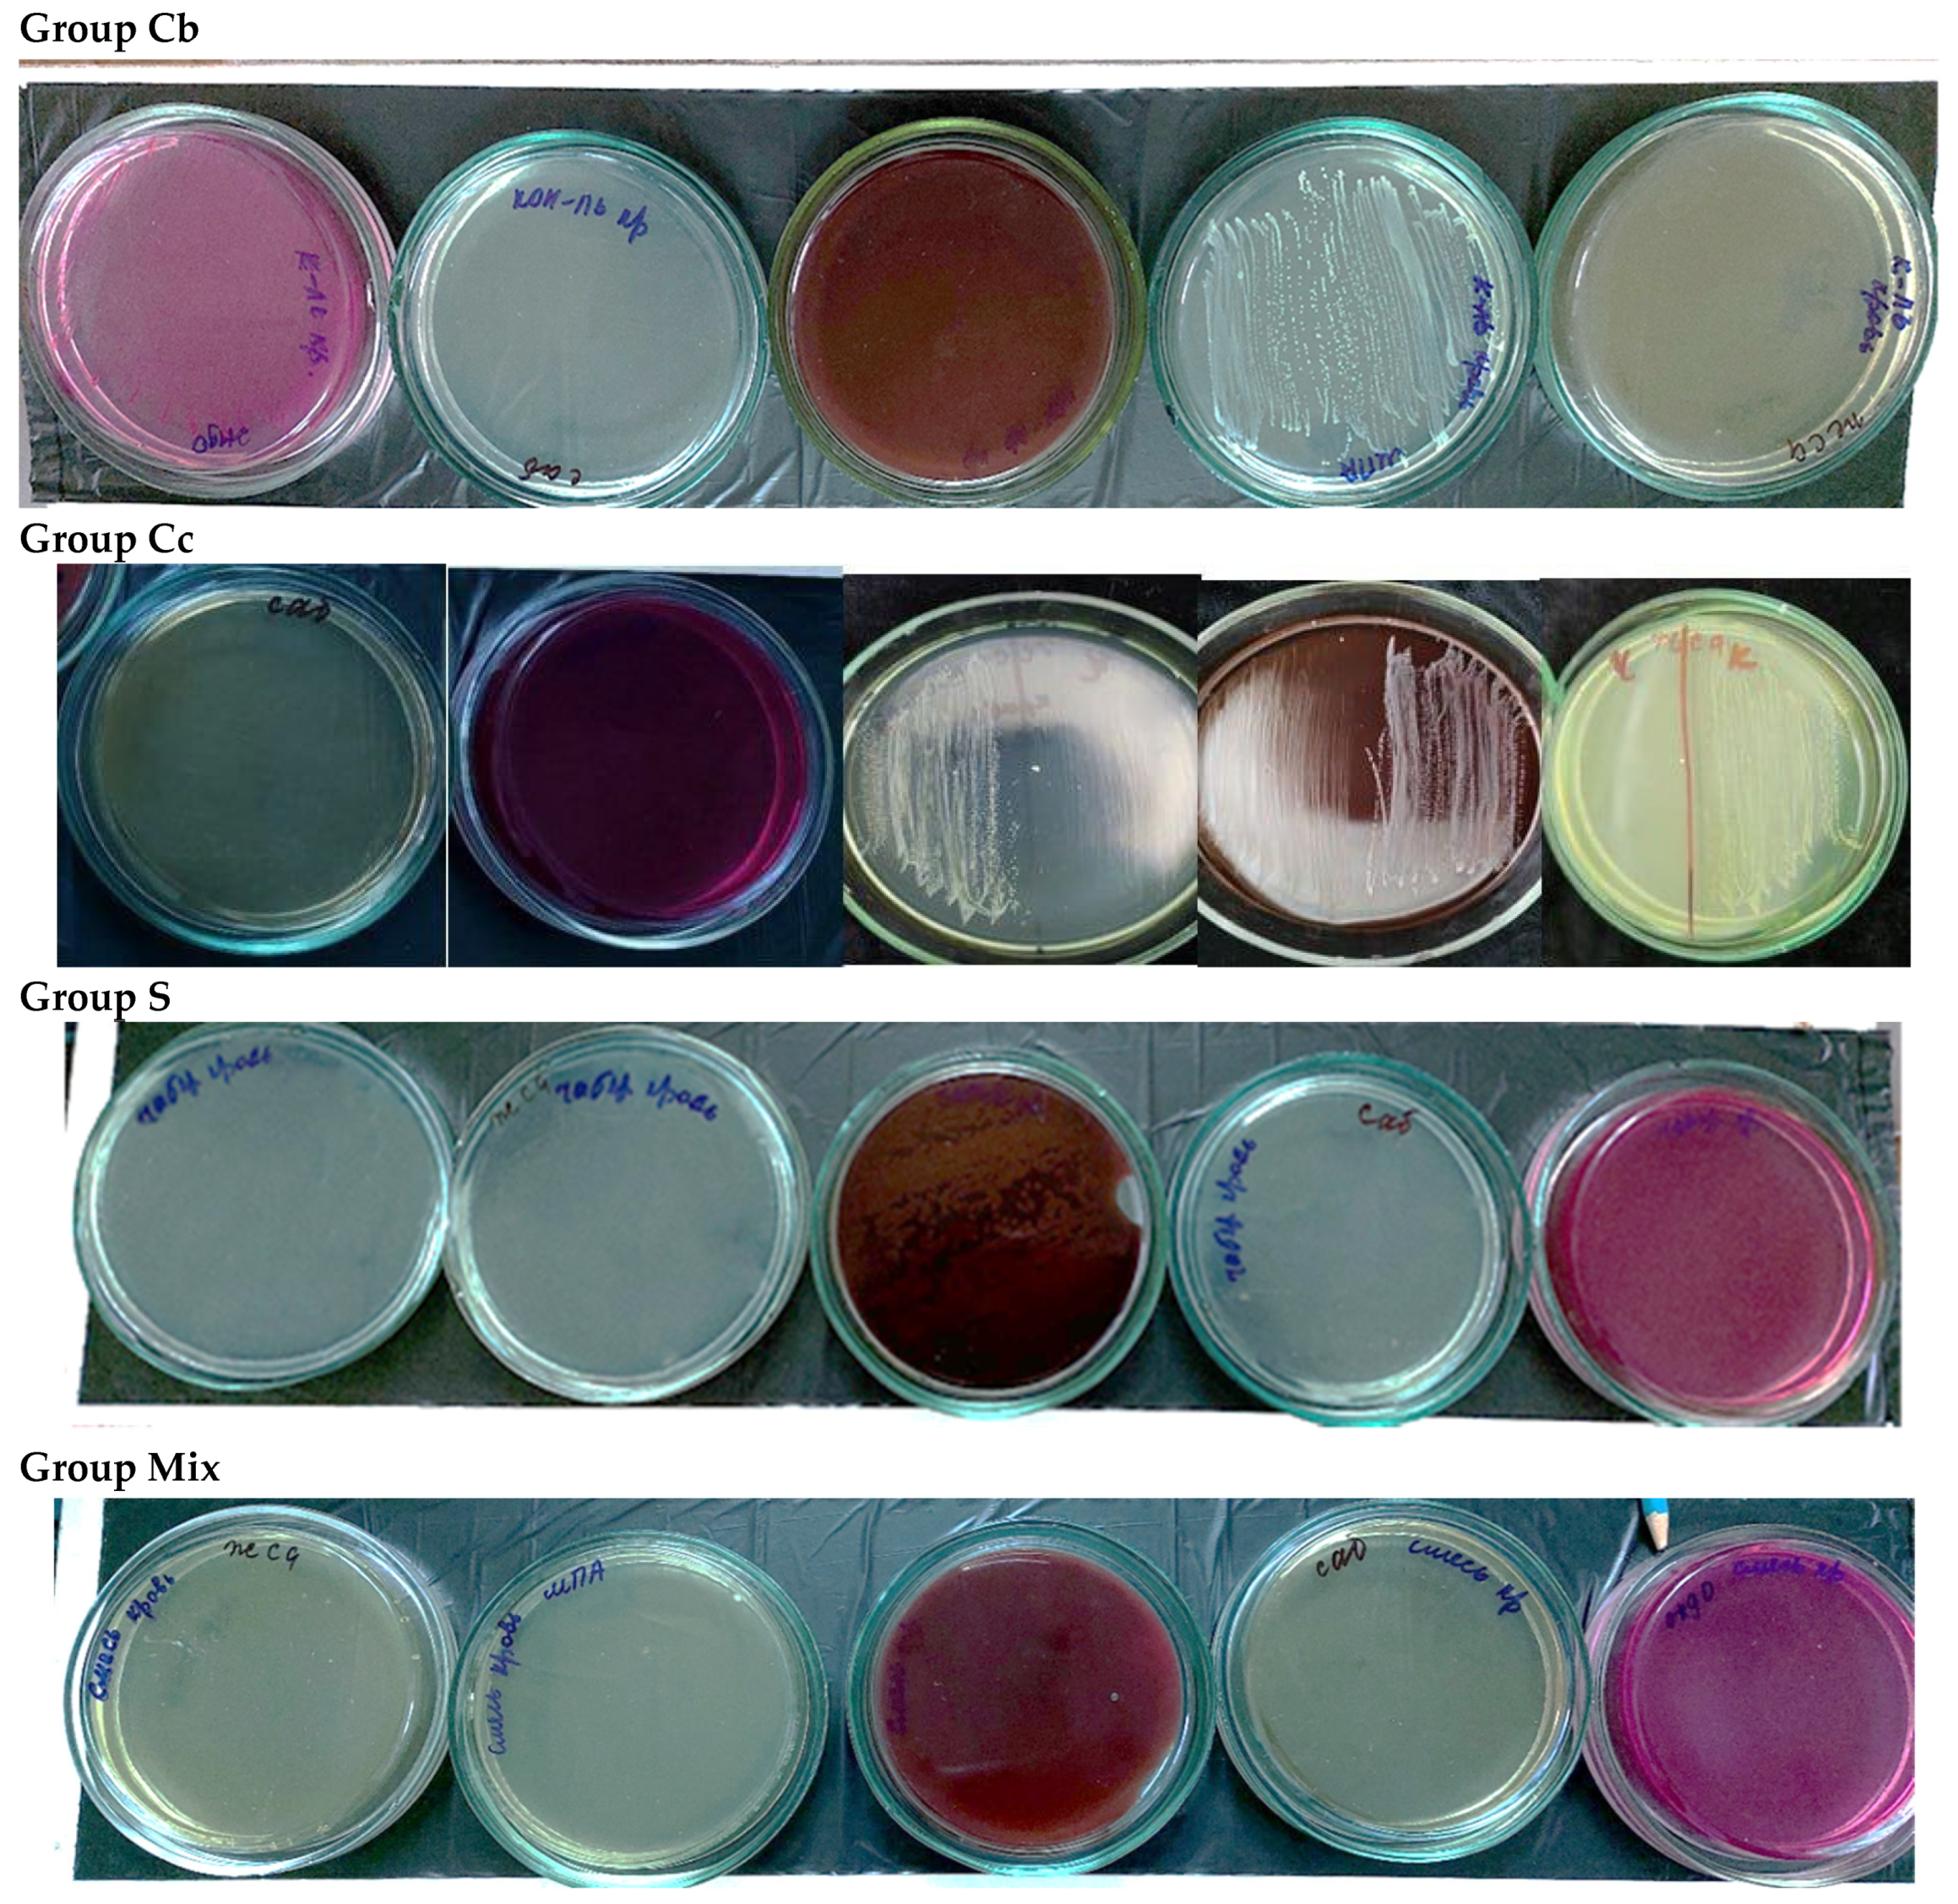
Ijms 25 08990 g001

Burn Wound Healing Activity of Hydroxyethylcellulose Gels with Different Water Extracts Obtained from Various Medicinal Plants in Pseudomonas aeruginosa-Infected Rabbits
Abstract
1. Introduction
2. Research Objective
Research Tasks
- To evaluate the reparative potential of the epidermis based on the expression levels of the proliferation factor (Ki-67).
- To assess the state of local immunity based on the number of CD-45 cells.
- To establish the anti-inflammatory role of mast cells based on levels of tryptase distribution.
3. Results
3.1. Macroscopic Description
3.2. Morphological Examination
3.3. Immunohistochemical Examination
4. Discussion
Study Limitations
5. Materials and Methods
5.1. Medicinal Plant Water Extracts and Gel Preparation
5.2. Immunohistochemical Study
6. Conclusions
Author Contributions
Funding
Institutional Review Board Statement
Informed Consent Statement
Data Availability Statement
Conflicts of Interest
References
- Yang, N.; Shi, N.; Yao, Z.; Liu, H.; Guo, W. Gallium-modified gelatin nanoparticles loaded with quercetin promote skin wound healing via the regulation of bacterial proliferation and macrophage polarization. Front. Bioeng. Biotechnol. 2023, 11, 1124944. [Google Scholar] [CrossRef]
- Awuor, S.; Mariita, R.; Omwenga, E.; Musila, J.; Musyoki, S. Monitoring the battleground: Antimicrobial resistance, antibiofilm patterns, and virulence factors of wound bacterial isolates from patients in hospital system. medRxiv 2023. preprint. [Google Scholar] [CrossRef]
- Pfalzgraff, A.; Brandenburg, K.; Weindl, G. Antimicrobial Peptides and Their Therapeutic Potential for Bacterial Skin Infections and Wounds. Front. Pharmacol. 2018, 9, 281. [Google Scholar] [CrossRef] [PubMed]
- Bahramsoltani, R.; Farzaei, M.H.; Rahimi, R. Medicinal plants and their natural components as future drugs for the treatment of burn wounds: An integrative review. Arch. Dermatol. Res. 2014, 306, 601–617. [Google Scholar] [CrossRef] [PubMed]
- Puca, V.; Marulli, R.; Grande, R.; Vitale, I.; Niro, A.; Molinaro, G.; Prezioso, S.; Muraro, R.; Giovanni, P. Microbial Species Isolated from Infected Wounds and Antimicrobial Resistance Analysis: Data Emerging from a Three-Years Retrospective Study. Antibiotics 2021, 10, 1162. [Google Scholar] [CrossRef] [PubMed]
- Boateng, J.; Catanzano, O. Advanced Therapeutic Dressings for Effective Wound Healing—A Review. J. Pharm. Sci. 2015, 104, 3653–3680. [Google Scholar] [CrossRef] [PubMed]
- Ouahdani, K.; Es-safi, I.; Mechchate, H.; Al-Zahrani, M.; Qurtam, A.; Aleissa, M.; Bari, A.; Bousta, D. Thymus algeriensis and Artemisia herba-alba Essential Oils: Chemical Analysis, Antioxidant Potential and In Vivo Anti-Inflammatory, Analgesic Activities, and Acute Toxicity. Molecules 2021, 26, 6780. [Google Scholar] [CrossRef] [PubMed]
- Silva, J.; Abebe, W.; Sousa, S.; Duarte, V.; Machado, M.; Matos, F. Analgesic and anti-inflammatory effects of essential oils of Eucalyptus. J. Ethnopharmacol. 2003, 89, 277–283. [Google Scholar] [CrossRef] [PubMed]
- Van Yperen, D.T.; Van Lieshout, E.M.; Nugteren, L.H.; Plaisier, A.C.; Verhofstad, M.H.; Van der Vlies, C.H. Adherence to the emergency management of severe burns referral criteria in burn patients admitted to a hospital with or without a specialized burn center. Burns 2021, 47, 1810–1817. [Google Scholar] [CrossRef]
- Sumner, J.P.; Pucheu-Haston, C.M.; Fowlkes, N.; Merchant, S. Dorsal skin necrosis secondary to a solar-induced thermal burn in a brown-coated dachshund. Can. Vet. J. 2016, 57, 305–308. [Google Scholar] [PubMed]
- Radwan-Pragłowska, J.; Janus, Ł.; Piątkowski, M.; Sierakowska, A.; Matysek, D. ZnO nanorods functionalized with chitosan hydrogels crosslinked with azelaic acid for transdermal drug delivery. Colloids Surf. B Biointerfaces 2020, 194, 111170. [Google Scholar] [CrossRef] [PubMed]
- Heidari, M.; Bahramsoltani, R.; Abdolghaffari, A.H.; Rahimi, R.; Esfandyari, M.; Baeeri, M.; Hassanzadeh, G.; Abdollahi, M.; Farzaei, M.H. Efficacy of topical application of standardized extract of Tragopogon graminifolius in the healing process of experimental burn wounds. J. Tradit. Complement. Med. 2018, 9, 54–59. [Google Scholar] [CrossRef]
- Bogdanova, S.A.; Kopaneva, M.S. Colloid-chemical properties of cosmetics with water extracts. Bull. Kazan Technol. Univ. 2017, 20, 14–16. (In Russian) [Google Scholar]
- Burtseva, E.V.; Kuldyrkaeva, E.V.; Mekhonoshina, I.S.; Timasheva, L.A.; Pekhova, O.A.; Katsev, A.M. Study of the chemical composition and biological action of Hyssopus officinalis L. water extract. Med.-Pharm. J. Puls 2023, 25, 25–34. (In Russian) [Google Scholar]
- Kalita, S.; Kandimalla, R.; Devi, B.; Kalita, B.; Kalita, K.; Deka, M.; Kataki, A.C.; Sharma, A.; Kotoky, J. Dual delivery of chloramphenicol and essential oil by poly-ε-caprolactone–Pluronic nanocapsules to treat MRSA-Candida co-infected chronic burn wounds. RSC Adv. 2017, 7, 1749–1758. [Google Scholar] [CrossRef]
- Prusinowska, R.; Śmigielski, K.; Stobiecka, A.; Kunicka-Styczyńska, A. Hydrolates from lavender (Lavandula angustifolia)—Their chemical composition as well as aromatic, antimicrobial and antioxidant properties. Nat. Prod. Res. 2016, 30, 386–393. [Google Scholar] [CrossRef] [PubMed]
- Aćimović, M.G.; Tešević, V.V.; Smiljanić, K.T.; Cvetković, M.T.; Stanković, J.M.; Kiprovski, B.M.; Sikora, V.S. Hydrolates: By-products of essential oil distillation: Chemical composition, biological activity and potential uses. Adv. Technol. 2020, 9, 54–70. [Google Scholar] [CrossRef]
- Garzoli, S.; Petralito, S.; Ovidi, E.; Turchetti, G.; Masci, V.L.; Tiezzi, A.; Trilli, J.; Cesa, S.; Casadei, M.A.; Giacomello, P.; et al. Lavandula x intermedia essential oil and hydrolate: Evaluation of chemical composition and antibacterial activity before and after formulation in nanoemulsion. Ind. Crops Prod. 2020, 145, 112068. [Google Scholar] [CrossRef]
- Asif, M.; Saleem, M.; Saadullah, M.; Yaseen, H.; Zarzour, R. COVID-19 and therapy with essential oils having antiviral, anti-inflammatory, and immunomodulatory properties. Inflammopharmacology 2020, 28, 1153–1161. [Google Scholar] [CrossRef]
- Skočibušić, M.; Bezić, N. Chemical Composition and Antidiarrhoeal Activities of Winter Savory (Satureja montana L.) Essential Oil. Pharm. Biol. 2003, 41, 622–626. [Google Scholar] [CrossRef]
- Lapina, A.S.; Varina, N.R.; Kurkin, V.A.; Avdeeva, E.V.; Ryazanova, T.K.; Ryzhov, V.M.; Ruzaeva, I.V. Monarda fistulosa as a promising source of medicinal products. Biol. Plants Hortic. Theory Innov. 2018, 175–178. (In Russian) [Google Scholar] [CrossRef]
- Zhilyakova, E.T.; Novikov, O.O.; Naumenko, E.N.; Kuzmicheva, O.A.; Bocharova, K.A.; Titareva, L.V. Study of the antimicrobial and anti-inflammatory activity of a new medicinal form with monarda oil. Scientific Notes of Belgorod State University. Med. Pharm. 2013, 24, 198–201. (In Russian) [Google Scholar]
- Naumenko, E.N.; Zhilyakova, E.T.; Novikov, O.O.; Krichkovskaya, L.V.; Timoshenko, E.Y.; Stupakov, A.G. Study of the immunomodulatory activity of Monarda fistulosa essential oil. Reg. Geosystems 2012, 21, 154–158. (In Russian) [Google Scholar]
- Shen, Q.; Zhou, W.; Li, H.; Hu, L.; Mo, H. ROS Involves the Fungicidal Actions of Thymol against Spores of Aspergillus flavus via the Induction of Nitric Oxide. PLoS ONE 2016, 11, e0155647. [Google Scholar] [CrossRef] [PubMed]
- Katoch, M.; Pull, S. Endophytic fungi associated with Monarda citriodora, an aromatic and medicinal plant and their biocontrol potential. Pharm. Biol. 2017, 55, 1528–1535. [Google Scholar] [CrossRef] [PubMed]
- Inouye, S.; Takahashi, M.; Abe, S. Inhibitory activity of hydrosols, herbal teas and related essential oils against filament formation and the growth of Candida albicans. Nihon Ishinkin Gakkai zasshi. Jpn. J. Med. Mycol. 2009, 50, 243–251. [Google Scholar] [CrossRef]
- Xiao, C.W.; Liu, Y.; Wei, Q.; Ji, Q.A.; Li, K.; Pan, L.J.; Bao, G.L. Inhibitory Effects of Berberine Hydrochloride on Trichophyton mentagrophytes and the Underlying Mechanisms. Molecules 2019, 24, 742. [Google Scholar] [CrossRef] [PubMed]
- Nersesyan, Z.M.; Parkhomenko, A.Y.; Pogorely, V.E.; Makarova, L.M.; Oganesyan, E.T. Chemical composition and pharmacological activity of Coriandrum sativum herb extract. Proceedings of Higher Educational Institutions. North Caucasus Region. Nat. Sci. 2006, 49–51. (In Russian) [Google Scholar]
- Hwang, E.; Lee, D.-G.; Park, S.H.; Oh, M.S.; Kim, S.Y. Coriander leaf extract exerts antioxidant activity and protects against UVB-induced photoaging of skin by regulation of procollagen type I and MMP-1 expression. J. Med. Food 2014, 17, 985–995. [Google Scholar] [CrossRef]
- Pashtetskiy, V.S.; Nevkrytaya, N.V. Use of essential oils in medicine, aromatherapy, veterinary medicine, and plant growing (review). Tavricheskiy Vestn. Agrar. Nauk. 2013, 16–38. (In Russian) [Google Scholar] [CrossRef]
- Zhilyakova, E.T.; Novikov, O.O.; Naumenko, E.N.; Krichkovskaya, L.V.; Polukhina, T.S.; Timoshenko, Y.Y.; Novikova, M.Y.; Litvinov, S.A. Study of low-molecular-weight biologically active compounds of plant origin as promising agents for the prevention and treatment of seborrhea. Kuban. Nauchnyy Meditsinskiy Vestn. 2010, 122, 68–72. (In Russian) [Google Scholar]
- Duke, J.A. Handbook of Medicinal Herbs; CRC Press: Boca Raton, FL, USA, 1989; p. 273. [Google Scholar]
- Renaud, E.N.C.; Charles, D.J.; Simon, J.E. Essential oil quantity and composition from 10 cultivars of organically grown lavender and lavandin. J. Essent. Oil Res. 2001, 13, 269–273. [Google Scholar] [CrossRef]
- Šilha, D.; Švarcová, K.; Bajer, T.; Královec, K.; Tesařová, E.; Moučková, K.; Pejchalová, M.; Bajerová, P. Chemical Composition of Natural Hydrolates and Their Antimicrobial Activity on Arcobacter-Like Cells in Comparison with Other Microorganisms. Molecules 2020, 25, 5654. [Google Scholar] [CrossRef]
- Bakova, N.N.; Sataeva, T.P.; Postnikova, O.N.; Feskov, S.A.; Fedotova, I.A.; Suslova, A.A. Physico-chemical composition and biological activity of water extracts from new varieties of thyme. Bull. State Nikitsk. Bot. Gard. 2023, 37–48. (In Russian) [Google Scholar] [CrossRef]
- Kuevda, T.; Sataieva, T.; Ostapchuk, P.; Usmanova, E.; Zubochenko, D.; Zubochenko, A.; Pikhtereva, A.; Postnikova, O.; Shevkoplyas, L.; Logadyr, T. Satureja montana L. Essential Oil Influence on the Blood Component Composition and the Serum Bactericidal; Springer: Berlin/Heidelberg, Germany, 2023; pp. 1724–1731. [Google Scholar] [CrossRef]
- Demo, M.; Oliva, M.d.L.M.; López, M.L.; Zunino, M.P.; Zygadlo, J.A. Antimicrobial Activity of Essential Oils Obtained from Aromatic Plants of Argentina. Pharm. Biol. 2005, 43, 129–134. [Google Scholar] [CrossRef]
- Anis, A.; Sharshar, A.; El Hanbally, S.; Sadek, Y. A Novel Organic Composite Accelerates Wound Healing: Experimental and Clinical Study in Equine. J. Equine Vet.-Sci. 2021, 99, 103406. [Google Scholar] [CrossRef]
- Prządka, P.; Kuberka, M.; Skrzypczak, P.; Kiełbowicz, Z. Healing of a large skin defect in a dog with concurrent ozonated olive oil application. J. Small Anim. Pract. 2022, 63, 492. [Google Scholar] [CrossRef]
- Hammam, W.E.; Gad, A.M.; Gad, M.K.; Kirollos, F.N.; Yassin, N.A.; El Tantawi, M.E.; El Hawary, S.S.E. Pyrus communis L. (Pear) and Malus domestica Borkh. (apple) leaves lipoidal extracts as sources for beta-sitosterol rich formulae and their wound healing evaluation. Nat. Prod. Res. 2022, 37, 2613–2617. [Google Scholar] [CrossRef] [PubMed]
- Anis, A.; Sharshar, A.; El Hanbally, S.; Shehata, A.A. Histopathological Evaluation of the Healing Process of Standardized Skin Burns in Rabbits: Assessment of a Natural Product with Honey and Essential Oils. J. Clin. Med. 2022, 11, 6417. [Google Scholar] [CrossRef] [PubMed]
- Abdelshafeek, K.A.; Osman, A.F.; Mouneir, S.M.; Elhenawy, A.A.; Abdallah, W.E. Phytochemical profile, comparative evaluation of Satureja montana alcoholic extract for antioxidants, anti-inflammatory and molecular docking studies. BMC Complement. Med. Ther. 2023, 23, 108. [Google Scholar] [CrossRef] [PubMed]
- Norman, G.; Christie, J.; Liu, Z.; Westby, M.J.; Jefferies, J.M.; Hudson, T.; Edwards, J.; Mohapatra, D.P.; Hassan, I.A.; Dumville, J.C. Antiseptics for burns. Cochrane Database Syst. Rev. 2017, 2017, 011821. [Google Scholar] [CrossRef] [PubMed]
- El-Sherbeni, S.A.; Negm, W.A. The wound healing effect of botanicals and pure natural substances used in in vivo models. Inflammopharmacology 2023, 31, 755–772. [Google Scholar] [CrossRef] [PubMed]
- Al-Madhagy, S.A.; Mostafa, N.M.; Youssef, F.S.; Awad, G.E.A.; Eldahshan, O.A.; Singab, A.N.B. Metabolic profiling of a polyphenolic-rich fraction of Coccinia grandis leaves using LC-ESI-MS/MS and in vivo validation of its antimicrobial and wound healing activities. Food Funct. 2019, 10, 6267–6275. [Google Scholar] [CrossRef]
- Prussin, C.; Metcalfe, D.D. IgE, mast cell, basophils and eosinophils. J. Allergy Clin. Immunol. 2003, 111, 486–494. [Google Scholar] [CrossRef]
- Oehmichen, M.; Gronki, T.; Meissner, C.; Anlauf, M.; Schwark, T. Mast cell reactivity at the margin of human skin wounds: An early cell marker of wound survival? Forensis Sci. Int. 2009, 191, 1–5. [Google Scholar] [CrossRef] [PubMed]
- Rüger, B.; Dunbar, P.R.; Hasan, Q.; Sawada, H.; Kittelberger, R.; Greenhill, N.; Neale, T.J. Human mast cells produce type VIII collagen in vivo. Int. J. Exp. Pathol. 1994, 75, 397–404. [Google Scholar] [PubMed]
- Crivellato, E.; Beltrami, C.A.; Mallardi, F.; Ribatti, D. The mast cell: An active participant or an innocent bystander? Histol. Histopathol. 2004, 19, 259–270. [Google Scholar]
- Mantis, P.; Lloyd, D.H.; Pfeiffer, D.; Stevens, K.; Auxilia, S.; Noli, C.; Abramo, F.; Miolo, A. Assessment of the effect of an aliamide-containing topical gel by evaluation of the reduction of wound volume measured by high resolution ultrasound biomicroscopy. Wounds 2007, 19, 113–119. [Google Scholar]
- Xiang, Z.; Block, M.; Löfman, C.; Nilsson, G. IgE-mediated mast cell degranulation and recovery monitored by time-lapse photography. J. Allergy Clin. Immunol. 2001, 108, 116–121. [Google Scholar] [CrossRef]
- Vázquez, T.A.S.; López, N.L.; Carmona, M.C.S. MASTer cell: Chief immune modulator and inductor of antimicrobial immune response. Front. Immunol. 2024, 15, 1360296. [Google Scholar] [CrossRef] [PubMed]
- Duran, V.; Matic, M.; Jovanovć, M.; Mimica, N.; Gajinov, Z.; Poljacki, M.; Boza, P. Results of the clinical examination of an ointment with marigold (Calendula officinalis) extract in the treatment of venous leg ulcers. Int. J. Tissue React. 2005, 27, 101–106. [Google Scholar] [PubMed]
- Kumar, M.; Keshwania, P.; Chopra, S.; Mahmood, S.; Bhatia, A. Therapeutic Potential of Nanocarrier-Mediated Delivery of Phytoconstituents for Wound Healing: Their Current Status and Future Perspective. AAPS PharmSciTech 2023, 24, 155, Erratum in AAPS PharmSciTech 2023, 24, 206. [Google Scholar] [CrossRef] [PubMed]
- Asante-Kwatia, E.; Adjei, S.; Jibira, Y.; Gyimah, L.; Adjei-Hinneh, G.; Amponsah, I.K.; Mensah, A.Y. Amphimas pterocarpoides harms.: An Evaluation of flavonoid and phenolic contents, wound healing, anthelmintic and antioxidant activities of the leaves and stem bark. Heliyon 2021, 7, e08261. [Google Scholar] [CrossRef] [PubMed]
- Govindarajan, R.; Vijayakumar, M.; Rao, C.V.; Shirwaikar, A.; Mehrotra, S.; Pushpangadan, P. Healing potential of Anogeissus latifolia for dermal wounds in rats. Acta Pharm. 2004, 54, 331–338. [Google Scholar]
- Sawatdee, S.; Choochuay, K.; Chanthorn, W.; Srichana, T. Evaluation of the topical spray containing Centella asiatica extract and its efficacy on excision wounds in rats. Acta Pharm. 2016, 66, 233–244. [Google Scholar] [CrossRef]
- Diniz, L.R.L.; Calado, L.L.; Duarte, A.B.S.; de Sousa, D.P. Centella asiatica and Its Metabolite Asiatic Acid: Wound Healing Effects and Therapeutic Potential. Metabolites 2023, 13, 276. [Google Scholar] [CrossRef]

| Culture Medium’s Name | Group Cb | Group S | Group SA | Group SAM | Group Mix | Group M |
|---|---|---|---|---|---|---|
| MPA | Small, translucent colonies, R-form, G-rods subcultured on the IGLA correspond to E. coli growth type, oxidase-. | Lack of growth | Lack of growth | Insignificant amount of small, translucent colonies, R-form | Lack of growth | Lack of growth |
| Blood agar | Greenish–grayish small colonies with an uneven edge on IGLA and endo growth correspond to E. coli | Lack of growth | Lack of growth | Lack of growth | Lack of growth | Lack of growth |
| Endo | Small colonies with a metallic sheen on the IGLA, growth is typical for E. coli | Lack of growth | Lack of growth | Lack of growth | Lack of growth | Lack of growth |
| YSA | Lack of growth | Lack of growth | Lack of growth | Lack of growth | Lack of growth | Lack of growth |
| Sabouraud | Lack of growth | Lack of growth | Lack of growth | Lack of growth | Lack of growth | Lack of growth |
| Experimental Group | Period of the Experiment, Day | ||||
|---|---|---|---|---|---|
| P | 3 | 7 | 10 | 14 | 21 |
| SA | - | - | 2.2 | 4.2 | 7.2 |
| S | - | 2.7 | 3,4 | - | 3.3 |
| SAM | 8.6 | - | - | 13.1 | 12.4 |
| Mix | - | - | 3.4 | 2.4 | 1.2 |
| M | 9.2 | 4.5 | 4.2 | - | - |
| Cb | 4.2 | - | 3.4 | 3.5 | - |
| Experimental Group | Period of the Experiment, Day | ||||
|---|---|---|---|---|---|
| 3 | 7 | 10 | 14 | 21 | |
| SA | - | - | 3.7 | 2.4 | 6.8 |
| S | - | 0.5 | 1.4 | - | 1.7 |
| SAM | 5.4 | - | - | 5.3 | 2.1 |
| Mix | - | - | 0.3 | 0.4 | 0.6 |
| M | 4.2 | 1.4 | 3.8 | - | - |
| Cb | 0.5 | - | 2.3 | 3.2 | - |
| No. | Group, Name | Quantity, n | Manipulations Performed |
|---|---|---|---|
| I | Control group 1 (Ca) | 10 | An intact group of animals that have not been burned and are in the same conditions as experimental animals. |
| II | Control group 2 (Cb) | 6 | A group of animals that received a thermal skin burn of the IIIa degree without treatment. |
| III | Control group 3 (Cc) | 6 | A group of animals with skin burns of the IIIa degree, followed by traditional treatment of the wound with boric acid and applying a napkin soaked with betadine with levomecol. |
| IV | Experimental group (S) | 6 | A group of animals with a IIIa burn followed by topical wound treatment with a gel based on mountain savory water extract (Satureja montana L.). |
| V | Experimental group (SA) | 6 | A group of animals with a IIIa skin burn followed by wound treatment with the gel based on mountain savory (Satureja montana L.) and aloe (Áloë vera) water extracts in a ratio of 1:1. |
| VI | Experimental group (SAM) | 6 | A group of animals with grade IIIa skin burn followed by wound treatment with the gel based on mountain savory (Saturej amontana L.) and aloe (Áloë vera) water extracts in a ratio of 1:1, and oral administration of aqueous myrtle leaf macerate (Myrtus communis L.) in a dilution of 1:100 (2 mL of water extract per 200 mL of water). |
| VII | Experimental group (Mix) | 6 | A group of animals with a IIIa burn followed by wound treatment with the gel made from a mixture of water extracts of savory (Satureja montana L.), sage (Salvia sclarea), coriander (Coriandrum sativum L.), and lavender (Lavandula angustifolia) in equal proportions of 1:1:1:1. |
| VIII | Experimental group (M) | 6 | A group of animals with a grade IIIa skin burn followed by wound treatment with the gel based on mountain savory water extract (Satureja montana L.) and monarda (Monarda fistulosa) in a ratio of 1:1. |
Disclaimer/Publisher’s Note: The statements, opinions and data contained in all publications are solely those of the individual author(s) and contributor(s) and not of MDPI and/or the editor(s). MDPI and/or the editor(s) disclaim responsibility for any injury to people or property resulting from any ideas, methods, instructions or products referred to in the content. |
© 2024 by the authors. Licensee MDPI, Basel, Switzerland. This article is an open access article distributed under the terms and conditions of the Creative Commons Attribution (CC BY) license (https://creativecommons.org/licenses/by/4.0/).
Share and Cite
Demyashkin, G.; Sataieva, T.; Shevkoplyas, L.; Kuevda, T.; Ahrameeva, M.; Parshenkov, M.; Mimuni, A.; Pimkin, G.; Atiakshin, D.; Shchekin, V.; et al. Burn Wound Healing Activity of Hydroxyethylcellulose Gels with Different Water Extracts Obtained from Various Medicinal Plants in Pseudomonas aeruginosa-Infected Rabbits. Int. J. Mol. Sci. 2024, 25, 8990. https://doi.org/10.3390/ijms25168990
Demyashkin G, Sataieva T, Shevkoplyas L, Kuevda T, Ahrameeva M, Parshenkov M, Mimuni A, Pimkin G, Atiakshin D, Shchekin V, et al. Burn Wound Healing Activity of Hydroxyethylcellulose Gels with Different Water Extracts Obtained from Various Medicinal Plants in Pseudomonas aeruginosa-Infected Rabbits. International Journal of Molecular Sciences. 2024; 25(16):8990. https://doi.org/10.3390/ijms25168990
Chicago/Turabian StyleDemyashkin, Grigory, Tatiana Sataieva, Ludmila Shevkoplyas, Tatyana Kuevda, Maria Ahrameeva, Mikhail Parshenkov, Alexander Mimuni, Georgy Pimkin, Dmitrii Atiakshin, Vladimir Shchekin, and et al. 2024. "Burn Wound Healing Activity of Hydroxyethylcellulose Gels with Different Water Extracts Obtained from Various Medicinal Plants in Pseudomonas aeruginosa-Infected Rabbits" International Journal of Molecular Sciences 25, no. 16: 8990. https://doi.org/10.3390/ijms25168990
APA StyleDemyashkin, G., Sataieva, T., Shevkoplyas, L., Kuevda, T., Ahrameeva, M., Parshenkov, M., Mimuni, A., Pimkin, G., Atiakshin, D., Shchekin, V., Shegay, P., & Kaprin, A. (2024). Burn Wound Healing Activity of Hydroxyethylcellulose Gels with Different Water Extracts Obtained from Various Medicinal Plants in Pseudomonas aeruginosa-Infected Rabbits. International Journal of Molecular Sciences, 25(16), 8990. https://doi.org/10.3390/ijms25168990

